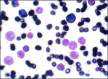

Generalised leukaemic gingival enlargement: a case report
- PMID: 24422017
- PMCID: PMC3886083
- DOI: 10.5037/jomr.2012.3305
Generalised leukaemic gingival enlargement: a case report
Abstract
Background: Acute myeloblastic leukaemia is a malignant bone marrow neoplasm of myeloid precursors of white blood cells. Due to its high morbidity rate, early diagnosis and appropriate medical therapy is essential.
Methods: The article highlights normal blood alterations like anaemia, thrombocytopenia, leukocytosis and advanced diagnostic aids like flow cytometry, special staining as a diagnostic modality as well as for prognostic information in acute leukaemia, particularly as a tool for assigning lineage and facilitating further pathologic classification which may be helpful in influencing treatment strategies.
Results: On clinical examination the case presented with features of inflammatory gingival enlargement with presence of local deposits and calculus. Routine blood examination anaemia, thrombocytopenia, leukocytosis with haemoglobin 5.6 gm% and total leukocyte count of 1,12,000 / cu mm suggestive of leukaemia. Myeloperoxidase and leukocyte nonspecific esterase (NSE) special stain were used which showed presence of myeloblasts in the peripheral smear suggestive of acute myelocytic leukaemia. Flow cytometry were done which further helped in interpretation of these cells which showed to be strongly positive for CD45, CD13, CD14, and anti HLADR and moderately positive for CD4, CD34 and Anti MPO confirming to be case of AML-M4 with 57.73% gating.
Conclusions: Fact that gingival alterations are sometimes the first manifestations of the disease implies that dental professionals must be sufficiently familiarized with the clinical manifestations of systemic diseases. The timely referral by the general dentist for a suspicious lesion provided an early diagnosis and early intervention reducing the patient morbidity.
Keywords: acute myeloid leukemia; flow cytometry; gingival hyperplasia..
Figures

References
-
- Cooper CL, Loewen R, Shore T. Gingival hyperplasia complicating acute myelomonocytic leukemia. J Can Dent Assoc. 2000 Feb;66(2):78-9. Review. - PubMed
-
- Eversole LR. Benign tumors of the oral cavity. In: Greenberg MS, Glick M, editors. Burket's Oral medicine: Diagnosis and treatment. 10th edition. Ontario: BC Decker Inc.; 2003. p. 137-94. URL: http://web.squ.edu.om/med-Lib/MED_CD/E_CDs/oral%20medicine/startme.pdf.
-
- Carranza FA, Hogan EL. Gingival enlargement. In: Newman MG, Takei HH, Carranza FA. Clinical periodontology. 10th edition. Philadelphia: WB Saunders Co; 2002. p. 279-96.
-
- Henderson ES. Definition and classification, in Henderson ES, Lister TA: Leukemia, 5th edition Philodelphia, WB Saunders Co; 1990. p. 13-5.
Publication types
LinkOut - more resources
Full Text Sources
Research Materials
Miscellaneous